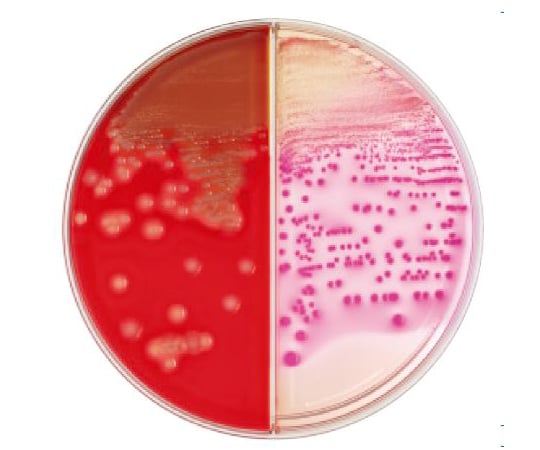

ブルセラ属の菌種を培養するための培地です。 5%ウマ血液を添加した培地は、培養条件が難しくない細菌および培養条件が難しい細菌を分離、培養するための定性法に使用します。 仕様 粉末培地;ブリタニカ国際大百科事典 小項目事典 血液寒天培地の用語解説 基礎培地に動物の血液を5~10%加えて均等に混合した寒天培地。多くの細菌の培養に用いられるが,特に肺炎球菌や化膿レンサ球菌のように栄養要求のきびしい菌種の培養に適している。アズワンのaxel 生培地 ポアメディア 羊血液寒天培地 10枚 emp35のコーナーです。axelは研究開発、医療介護、生産現場、食品衛生など幅広い分野に500万点以上の品揃えでお応えする商品サイト。3000円以上ご注文で送料無料。

血液寒天培地プレートに溶血性ベータ連鎖球菌細菌のコロニー の写真素材 画像素材 Image
血液寒天培地 白色コロニー
血液寒天培地 白色コロニー-27/09/19血液寒天培地 対象 ・普通寒天培地に発育できないような,栄養要求条件が厳しい細菌 備考 単に血液寒天培地といった場合, ヒツジ血液寒天培地 を表します。 以下に示す菌は血液寒天培地に発育できません。また古い教科書には, 黄色ブドウ球菌と対比させて培養集落 (マンニット食塩培地や血液寒天培地) の色から白色ブドウ球菌と記載してありますが, これも表皮ブドウ球菌 (S epidermidis) と同じ意味合いです。現在では, これらの表皮に生息する菌種を, 黄色ブドウ球菌と区別するために, 表皮ブドウ



変法cdc嫌気性菌用ヒツジ血液寒天培地 日本bd
非選択培地(ブルセラhk(rs)血液寒天培地)ビタミンk1,ヘミンを含み,嫌気性菌全般の分離培養に適している。 ヒツジ脱繊維血液の併用により, Cperfringens の逆CAMPテスト, Mobiluncus sp のスクリ-ニング及び同定キットの前培養にも適している。血液寒 天培地は臨床材料から的確に病原菌を検出し、正しい情報提供を行なう上で非 常に重要な役割を担っておりますことは言うまでもありません。それゆえ、使 用にあたっては培地の性能を正確に評価され、十分理解された上でご検討いたCCDA寒天培地(SEL) カンピロバクター選択分離用培地です。 カンピロバクターは灰色の湿潤したコロニーを形成します。 血液を使用しない処方となっているため血液添加培地に比べ、調製操作が容易であり安定性も良い培地です。 CCDA寒天培地の雑菌抑制
培地の発育は、チョコレート寒天培地は炭酸ガス 培養にて72時間で微小なコロニーが発育。一般的な 血液寒天培地には発育せず、ビタミンb2あるいはL -システインの添加された血液寒天培地(ヒツジ血 液寒天m58e‐mr93・栄研化学)と嫌気培養のブルセ9血液寒天培地に発育,ときにsc不能 9イヌ・ネコの口腔内常在菌 9咬傷/掻傷後の敗血症(致死率約30%) 9糖尿病,アルコール依存症,摘脾,高齢者 9各種抗菌薬の感受性は良好 9分離菌株は感染研の鈴木道雄先生へ 国立感染症研究所獣医科学部第一室( 内線2622)血液寒天培地に生える結核菌 溶血へのこだわり 溶血性が見れるのが血液寒天培地に課せられた最大のミッションです。 溶血と言っても緑色になるα溶血、コロニー周囲が抜けて見えるβ溶血がありますが、β溶血が血液寒天培地に求められる条件と
カンピロバクター無血液選択寒天基礎培地 (CCDA変法) のSDS(安全データシート)、CoA(試験成績書)およびCoQ(品質証明書)、カタログなど製品関連の技術資料を入手いただけます。 (M)SDS 試験成績書(CoA) カタログ 技術情報 データシート 証明書 pH/08/SCD寒天培地(ソイビーンカゼイン寒天培地) 普通寒天培地、標準寒天培地などと並び、選択性が低く、広範囲な菌を発育させることが出来る。 チョコレート寒天培地 (Chocolate agar, CHOC) 普通寒天に血液を加えてオートクレーブにかけた、チョコレート色の培地。これらの NAD や NADP 等の V 因子を破壊する酵素は, もちろんウマ・ウサギ血液を含む総ての動物種の赤血球中に認められるのですが, ウマ・ウサギの赤血球中には他の動物の赤血球と比較してその酵素量が著しく少ないのです。ですから, ウマ・ウサギ血液寒天培地では Haemophilus 属は発育可能なのです。でも, このウマ・ウサギ血液も加熱によりチョコレ-ト寒天培地に


Www Nissui Pharm Co Jp Pdf Products 510 P Pdf



Kbm ヒツジ血液寒天培地 コージンバイオ株式会社
羊血液寒天培地/ドリガルスキー改良培地 10枚 emr04極東製薬工業 生培地(バイタルメディア) 標準寒天培地 一般生菌数測定用 100入 5700 1箱(100枚) (直送品) 販売単位: 1箱 (100枚) お申込番号: お届け日: 5月27日(木)まで 直送品 アスクル指定出荷元からお届け 販売価格 (税抜き) ¥11,400 販売価格 (税込) ¥12,540 数量 1 2 3 4 5 6 7 8 9 10細菌検査のための 培地~基礎 まず初めにこの3つの培地を覚えましょう! とくにグラム陰性桿菌用培地のDHL寒天培地と グラム陽性球菌用培地の血液寒天培地は必須です。



細菌一般培養検査の基本的な培地は 血液寒天培地 チョコレート寒天培地および Btb乳糖加寒天培地 感染症の病理学的考え方


細菌検査のための 培地 基礎
GVPC寒天培地 ニッスイプレート レジオネラ属菌の選択分離用培地 特徴 環境水などから Legionella 属菌を選択分離できます。 Legionella 属菌の増殖発育因子として、Lシステイン塩酸塩と ピロリン酸第二鉄が添加されています。羊血液寒天培地hem sds 10枚 ¥1,800冷暗所(4~10℃) ・禁凍結 25ヶ月間 ニッスイプレート 羊血液寒天培地hem sds 100枚 ¥18,000冷暗所(4~10℃) ・禁凍結 25ヶ月間 ニッスイプレート 羊血液寒天培地ex sds 100枚 ¥25,000冷暗所(4~10℃) ・禁凍結 2ヶ月間分離培地 雑菌の生育を抑えるため抗菌薬を含む 分離培地 添加抗菌薬 備考 BordetGengou寒天培地(BG培地) 40 µg/ml CEX 自作可能 ボルデテラCFDN寒天培地(CFDN培 地) 4 µg/ml CFDN 8 µg/ml VCM 日研生物 シクロデキストリン寒天培地(CSM培 地) µg/ml CEX 自作可能



Amazon 日水製薬 生培地 ニッスイ分画 プレート 羊血液寒天 マッコンキー寒天培地 10枚 寒天培地 産業 研究開発用品 通販


八雲総合病院 写真で見るシリーズ その2 感染対策室さんの日記
日水製薬 生培地 ニッスイプレート 馬血液寒天培地 10枚が寒天培地ストアでいつでもお買い得。当日お急ぎ便対象商品は、当日お届け可能です。アマゾン配送商品は、通常配送無料(一部除く)。血液寒天培地 mixiユーザー 07年08月05日 2340 質問です。 私の施設では、血寒にウサギ血液を使用しています。 (自前で作成) そうすると、羊血寒で生えてこないインフルエンザ菌も生えてくるし、溶血もチェックできます。 ですので、チョコレート寒天を必要とせず、併用していません。 一般的に羊血寒とチョコ寒を併用する。 というのが主流だといわれて10/03/21「ヒツジ血液寒天培地」や「チョコレート hb 寒天培地」の一般分離用 培地をはじめ、グラム陽性菌用培地や、嫌気性菌用培地など豊富な ラインアップをご用意しております。 製品の選定にご活用下さい。



寒天培地 Wikiwand


Www Pref Kagawa Lg Jp Documents 25 8 Pdf
を行った。症例2 では,ヒツジ血液寒天培地に加え てチョコレート寒天培地とブルセラhk 寒天培地も 同時に使用した。ブルセラhk 寒天培地では24 時間 培養後に,チョコレート寒天培地では48 時間培養後 に微小な集落を認めたが,この時点でもヒツジ血液血液寒天培地 血液寒天培地 フリー画像 画像は明示的にパブリックドメインに置かれています。 このギャラリーからすべての画像をご希望に応じで使用可能で、私用および商用の用途に自由に使用できます。 注射器, 医学, 計測器, スティル ・ ライフTarshisが その血液寒天培地について発表した文 献1)~10)の 中で,結 核菌の薬剤感受性試験に関する報 告は3つ ある7)~9)。そのうちストレプトマイシン(以 下SM)に ついては,Herroldの 鶏卵寒天培地と血液 寒天培地とは密接に一致した感受性成績をもたらした



寒天培地 代表的な寒天培地 Weblio辞書


血液寒天培地プレート白で隔離 カットアウトのストックフォトや画像を多数ご用意 Istock
06/11/使用目的 "KBM"ヒツジ血液寒天培地は、標準寒天培地には発育しにくい菌種の培養、溶血反応の鑑別に使用されます。 本培地にはヒツジ脱繊維血液が5%量添加されています。 一般細菌は勿論、Streptococcus属 (レンサ球菌)に代表される栄養要求の厳しい菌など、広範囲の細菌が旺盛に発育します。 レンサ球菌の溶血環が明瞭で、的確な溶血反応が得られます。 α溶血β 溶血性レンサ球菌とは,グラム染色を行い光学顕微鏡下に観察しますと,図1のように一定方向に分裂・増殖してレンサ状に見えることを特徴とする細菌です。 また,本菌は図2に示すように,血液寒天培地を用いて 24時間,5%炭酸ガス培養を行なわないと,発育が非常に悪い菌です。ヒツジ血液寒天培地(M)は、臨床材料からの溶血レンサ球菌の分離培養、および溶血反応の鑑別、並びに栄養要求の厳しい細菌の分離培養に使用されます。 本培地は、定評あるBD製血液寒天培地の溶血反応に影響を与えずに、肺炎球菌等の発育支持能(コロニーの大きさ、および発育スピード)のみを高めたものです。 ヒツジ血液寒天培地(M)の特徴 立ち上がりの



Jpa 血液寒天培地及びその保存方法 Google Patents



金沢医療センター 臨床検査科 細菌検査
CCDA培地 カンピロバクター血液無添加選択寒天培地 (Oxoid)その他メーカーにより異な る名称で市販されているが基本はmodifified Charcoal Cefoperazon Desoxycholate Agarである。 基礎培地(Oxoid CM739)2275 gを500 mlの蒸留水に溶かしオートクレーブ(121 ℃、 15 min)する。1 血液寒天培地の検討 EHECの スクリーニングに溶血を指標とする 場合に用いる血液寒天培地を検討するため,自 家 製のBeutinら の羊血液寒天培地に市販の2種 の 羊血液寒天生培地(栄 研,BBL)を 加え,3培 地 上での大腸菌による溶血について比較を行った"KBM"改良カンピロバクター血液寒天培地は、臨床材料からのCampylobacter jejuni/coliの選択分離培養に用います。 選択性の改良により、Campylobacterの検出率が向上しました。 組成 (精製水1Lに対して) カゼインペプトン100g



第65回 19年 Am66 Am70 臨床検査技師国家試験ウラ解答



日々の検査から No 7 じんりんぎ 微生物研究班
を2 mlのSEB培地に投入し、37℃、一夜増菌し、分離培養する。 3.分離培養法 分離培養には、ヒツジまたはウマの脱繊維血液を5%の割合に添加した血液寒天平板 培地を用いる。血液の濃度が3%より低い場合はα溶血とβ溶血の区別がしにくい場合が ある。血液寒天培地での見分け方 大腸菌 クレブシエラ 大腸菌 クレブシエラ コロニー 大きさ 大 大 色 灰色 乳白色・つやあり 形状 r:ラフ(ギザギザ)が多い sスムース(つるつる) 不整形 ムコイド状 におい



びせいぶつけんさトリビア じんりんぎ 微生物研究班



ヒツジ血液寒天培地 M 日本bd



血液寒天培地イラスト 無料イラストなら イラストac



l Tm 変法cdc嫌気性菌用ヒツジ血液寒天培地 10枚 ベクトン ディッキンソン 培地 通販モノタロウ 2523



微生物と感染症診療 肺炎球菌 M Review



チョコレート寒天培地 Wikipedia



血液寒天培地の作り方 検査と技術 13巻5号 医書 Jp


培地物語 血液寒天培地 後編 溶血反応 グラム染色道場


白色細菌のコロニーは血液寒天培地上の培養成長は実験室病院で小さな光粒を含む白背景 ウイルスのストックフォトや画像を多数ご用意 Istock



血液寒天培地 医療の背景のサルモネラ腸炎菌細菌のコロニー の写真素材 画像素材 Image



髄膜炎菌肺炎の1例



生培地 微生物検査用試薬 装置 臨床検査分野 製品情報栄研化学


検査 厚生労働科学研究費補助金 新型インフルエンザ等新興 再興感染症研究事業 重症型のレンサ球菌 肺炎球菌感染症に対するサーベイランスの構築と病因解析 その診断 治療に関する研究



l Tm Pea添加アネロコロンビアrs血液寒天培地 e寒天培地 10枚 ベクトン ディッキンソン 培地 通販モノタロウ



a群溶血性レンサ球菌咽頭炎について 愛知県衛生研究所



フリー写真画像 ブルセラ菌細菌 栽培 羊血液寒天培地



Amazon 日水製薬 生培地 ニッスイプレート 羊血液寒天培地 10枚 寒天培地 産業 研究開発用品 通販



金沢医療センター 臨床検査科 細菌検査



血液寒天培地 Wikipedia


B溶血性レンサ球菌とは 8 細菌検査 厚生労働科学研究費補助金 新型インフルエンザ等新興 再興感染症研究事業 重症型のレンサ球菌 肺炎球菌感染症に対するサーベイランスの構築と病因解析 その診断 治療に関する研究



血液寒天培地の菌コロニーの混在 の写真素材 画像素材 Image


培地物語 血液寒天培地 前編 血液は何でも良いのか グラム染色道場



菌種別 Span Class P100italic Enterococcus Span 属 微生物検査 検査 診断matrix



バイタルメディア 羊血液寒天培地について 極東製薬工業株式会社 極東製薬工業株式会社



Kbm アネロrs血液寒天培地 コージンバイオ株式会社



63 6526 96 l Tm コロンビア5 ヒツジ血液寒天培地 枚 Axel アズワン


血液寒天培地プレート白で隔離のグループ カットアウトのストックフォトや画像を多数ご用意 Istock



4班 けんさせんこう2ねんせい


カンピロバクター培地 プレストン培地の色


血液寒天培地 ストックフォトと画像 Getty Images



血液寒天培地 看護師のための微生物学



血液寒天培地 医療の背景のサルモネラ腸炎菌細菌のコロニー の写真素材 画像素材 Image



Streptokinase産生について Ppt Download



血液寒天培地 乳酸菌の写真素材



菌種別 Span Class P100italic Proteus Span 属 微生物検査 検査 診断matrix


培養同定検査 臨床微生物検査 臨床検査 株式会社 東邦微生物病研究所



菌種別 Staphylococcus属 微生物検査 検査 診断matrix



変法cdc嫌気性菌用ヒツジ血液寒天培地 日本bd



1班 けんさせんこう2ねんせい



菌種別 Span Class P100italic Neisseria Span 属 微生物検査 検査 診断matrix



ヒツジ血液寒天培地 M 日本bd



医療講座2 感染症



Nosai道央 北海道中央農業共済組合 乳房炎の原因菌同定と薬剤感受性検査



Amazon 日水製薬 生培地 ニッスイ分画 プレート 羊血液寒天 マッコンキー寒天培地 100枚 寒天培地 産業 研究開発用品 通販



Cdc嫌気性菌用ヒツジ血液寒天培地 日本bd



4 25 Arcanobacterium Pyogenesその2 石山大のフィールドノート


細菌検査のための 培地 基礎


検査室タイムズ Tekari 臨床検査技術部



Ppt 消毒前 Powerpoint Presentation Free Download Id



Jpa 血液寒天培地及びその保存方法 Google Patents



Mycoplasma Hominis なにこれ見えない グラム染色 Gram Stain



フリー写真画像 グラム 負 ブルセラの菌細菌 成長 血液寒天培地



Tsaii5 ヒツジ血液寒天培地 チョコレートii寒天培地 Iプレート 日本bd



血液寒天培地 医療の背景のサルモネラ腸炎菌細菌のコロニー の写真素材 画像素材 Image



Jpa 血液寒天培地及びその保存方法 Google Patents


腸管系細菌 細菌の検査 各論 神奈川県衛生研究所



血液寒天培地の黄色ブドウ球菌細菌のコロニー の写真素材 画像素材 Image



フリー写真画像 グラム陰性 細菌病菌 Pseudomallei 血液寒天培地に増殖する細菌



Amazon 日水製薬 生培地 ニッスイ分画 プレート 羊血液寒天 ドリガルスキー改良培地 10枚 寒天培地 産業 研究開発用品 通販


培地物語 血液寒天培地 前編 血液は何でも良いのか グラム染色道場



Kbm ヒツジ血液寒天培地 コージンバイオ株式会社


血液寒天培地シャーレ マクロ撮影で Dnaのストックフォトや画像を多数ご用意 Istock



血液寒天培地イラスト 無料イラストなら イラストac



臨床向け嫌気性菌用培地 アネロrs血液寒天培地 コージンバイオ イプロス医薬食品技術


市販生培地の精度管理のいろは 使用者のための

63 6527 86 l Tm コロンビアcna5 ヒツジ血液寒天培地 マッコンキー 寒天培地 枚 Axel アズワン



血液寒天培地プレートに溶血性ベータ連鎖球菌細菌のコロニー の写真素材 画像素材 Image



製品詳細



フリー写真画像 細菌病菌 Thailandensis 血液寒天培地に増殖する細菌



第64回 18年 Am76 Am80 臨床検査技師国家試験ウラ解答


培地物語 血液寒天培地 前編 血液は何でも良いのか グラム染色道場



バイタルメディア 羊血液寒天培地について 極東製薬工業株式会社 極東製薬工業株式会社


Mac Conkey 血液寒天培地で細菌のコロニーの成長を見せて細菌培養プレートを手で開催 Dnaのストックフォトや画像を多数ご用意 Istock



血液寒天培地 の画像素材 科学 テクノロジーの写真素材ならイメージナビ



Kbm 改良カンピロバクター血液寒天培地 コージンバイオ株式会社


細菌検査のための 培地 基礎



血液寒天培地の作り方 検査と技術 9巻3号 医書 Jp


プロトセカ乳房炎の防除対策 十勝nosai


Mlcb寒天培地颗粒hbkp8760 250g 颗粒培养基 特色产品系列 海博生物商城



Pro Bioの効果について 基礎研究3 ゼンダマンラボ



菌種別 Span Class P100italic Klebsiella Span 属 微生物検査 検査 診断matrix



l Tm Tsa 5 ヒツジ血液寒天培地 Btb乳糖加寒天培地 ベクトン ディッキンソン Axel アズワン



6班 けんさせんこう2ねんせい



Kbm コロンビアcaヒツジ血液寒天培地 コージンバイオ株式会社



Jpa 血液寒天培地及びその保存方法 Google Patents


検査室タイムズ Tekari 臨床検査技術部
0 件のコメント:
コメントを投稿